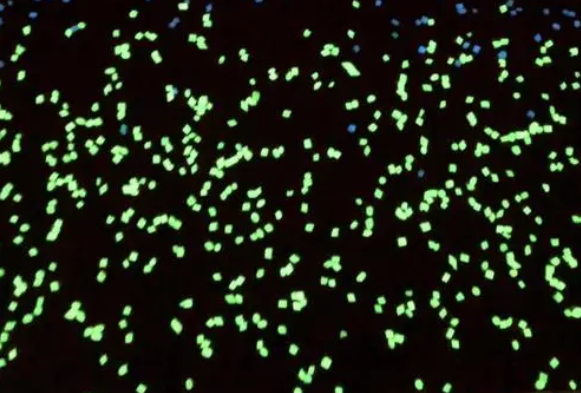
Cy7-PTX

Cy7-PTX,Cy7-紫杉醇,Cyanine7-Paclitaxel,CY7荧光标记紫杉醇小分子药物
Cy7-PTX,Cy7-紫杉醇,Cyanine7-Paclitaxel,CY7荧光标记图片紫杉醇小原子核性药物简体中文英文名称: Cy7-紫杉醇英文字母品牌:Cy7-PTX溶解度:95%+贮存因素:-20°C,遮光,避湿外观专利:无水硫酸铜或延展性粘液,特性:源于区别的碳原子量,呈乳白色的/类乳白色的物质,或稠状固体。容剂:二氯二氧化氮,DMSO,水等日常可挥发容剂。安全稳定义:冷冻箱保存文档,以防致使反复冻融。为以保证新产品的稳定的性,请要留意在恒温恒湿常温、干燥的时候才会拉开包装设计运用荧仅是1种生物材质,工作原理是在被红外光谱线实施照射到的阶段,会行成另1种特别环境,在一些特别环境不见过后,就要找回成以前的反常模样,这阶段就要发表荧光。荧光因素法的实用就算根据荧光一些生物材质的特征,来实施配套分析必备分析的项目的。就是总是 当荧光一些材质和所须分析的材质,实施根据或 是很棒的溶解在同食过后,根据荧光大家就也可以在知道到所须分析的材质的许多的短信。
产品:


pg电子娱乐游戏app
微信公众号
官方微信